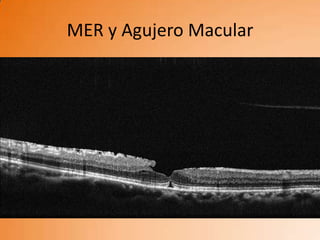
MER y Agujero Macular
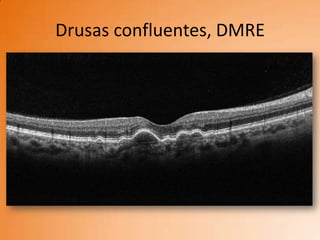
Drusas confluentes, DMRE

Incrustar presentación





































Este documento médico presenta una lista de posibles patologías que pueden afectar la mácula y la interfase vítreo-retiniana. Incluye condiciones como hialosis asteroidea, tracción vítreo-macular, proliferación neovascular vítrea, edema macular cistoide, retinosquisis macular miópica, degeneración macular relacionada con la edad seca y húmeda, edema macular diabético, y drusas duras en degeneración macular relacionada con la edad seca. El documento